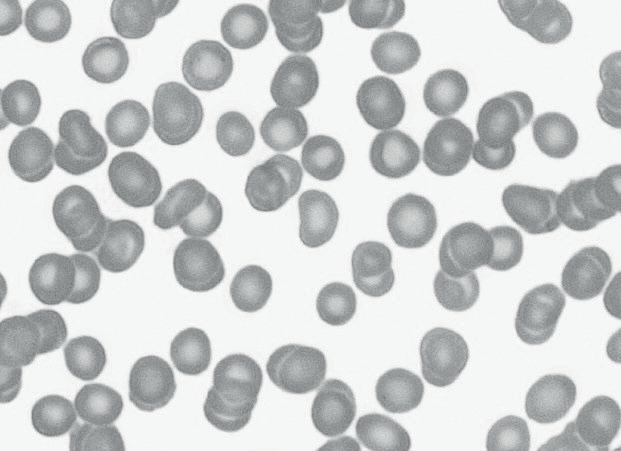
Embedded figure page 10

- The micrographs show red blood cells which were placed in salt solutions of different concentrations.
(a) Deduce with a reason the change in salt concentration from A to B that would result in the red blood cells shown in the micrographs. [2]
(b) Suggest a reason that no cells can be seen when blood samples are placed in distilled water. [1]